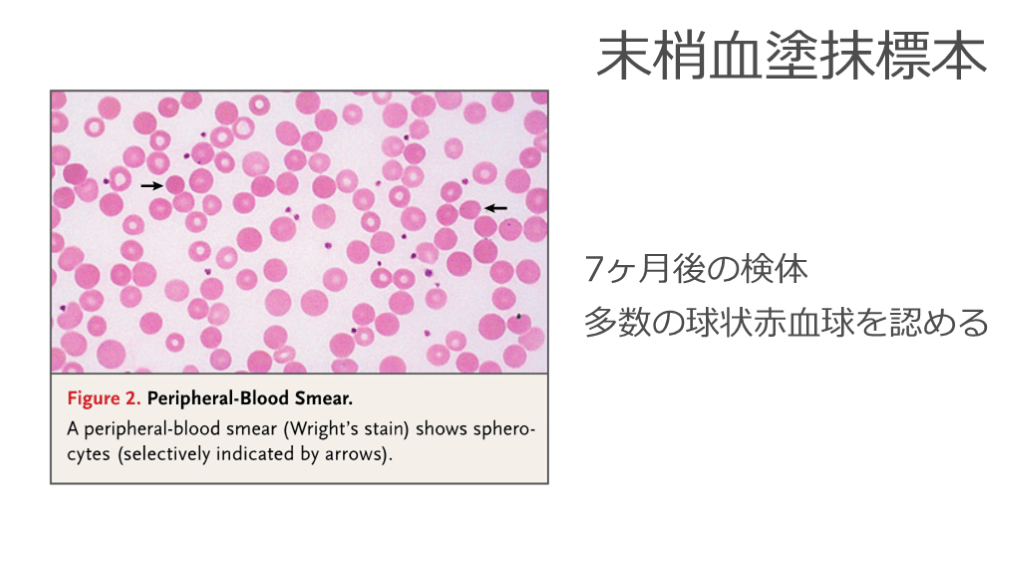

テキスト全文
東京曳舟病院 ER診断カンファレンスの概要
#1. 東京曳舟病院 救急科
藤原 翔 ER診断カンファレンス 〜Circling Back for the Diagnosis〜
腹痛を訴える28歳男性の病歴と症状
#3. 主訴:腹痛, 嘔気, 嘔吐
現病歴:6週間前から右上下腹部に断続的な痛みが続いている.食事で増悪し, 母親からもらった制酸剤を服用すると1~2時間で消退していた.
受診日は腹痛が8時間続き, 食後に増悪し,嘔吐を繰り返したためERを受診した. 症例 28歳男性
#4. 既往歴:Gilbert症候群 (2年前に近医で指摘)
非アルコール性脂肪肝, BMI 33
嗜好歴:喫煙歴なし, 機会飲酒 追加問診
#5. ROS(-):吐血, 胆汁様嘔吐, 下痢, 発熱, 悪寒
ROS(+):右上下腹部痛, 嘔気, 嘔吐 Review of System
#6. Onset:6週間前, 特に契機なし
Provocative/palliative factor:食事で増悪, 制酸剤で改善
Quality/quantity:断続的で波がある
Region/radiation:右上下腹部, 放散痛なし
Severity:痛みのため動けないほど
Time course:1〜2時間で消退する 痛みに関する追加問診
来院時の身体所見と初期評価
#7. 来院時現症 BP 145/90mmHg, PR 84bpm, BT 37.1℃, RR 18/min
SpO2 100%(room air)
GCS E4V5M6, 腹痛により苦悶様
眼球結膜黄染あり
呼吸音清, cracklesなし, 心雑音なし, gallop rhythmなし
右上下腹部に軽度の圧痛あり, 上腹部に強い
反跳痛なし, 筋性防御なし, 肝臓は触知せず
#8. # 6週間前からの右上腹部痛
# Gilbert症候群
# 非アルコール性脂肪肝
# 肥満 (BMI 33) Problem List
#9. System1直感的思考 第一印象と鑑別の最上位について考えて下さい
疾患名でなく病態の解釈でも良いです
最優先で欲しい問診項目についても
#10. Key Factは?
・6週間前からの右上下腹部痛
・食事で増悪する腹痛
・制酸剤で改善
・Gilbert症候群
・非アルコール性脂肪肝 System1直感的思考
右上腹部痛の鑑別診断と考察
#11. System1直感的思考 Impression
右上腹部痛がメインなら肝胆道系疾患
食後の増悪は, 胃潰瘍や胆石発作に典型的
1〜2時間で改善しており, 制酸剤による改善かは不明
Gilbert症候群は確定診断かは怪しい
#12. System1直感的思考 # 胆石疝痛発作
- 胆嚢炎, 胆管炎, 肝膿瘍
# 胃潰瘍
# 増悪寛解を繰り返している虫垂炎
腹部CTと超音波検査の結果
#14. ・肝腫大なし、脂肪肝
・脾腫あり (矢状断で16cm)
・胆石なし, 胆管拡張なし
・胆嚢の壁肥厚なし, 周囲の脂肪織濃度上昇なし
・虫垂の腫大なし 腹部単純CT 画像ありません...
#15. 腹部超音波 ・胆泥あり
・胆嚢壁の肥厚
・胆嚢周囲に少量の液貯留
・門脈, 肝静脈の血流は正常
#16. 急性胆嚢炎疑いとして入院となり、メロペネムが開始された.
入院2日目, 腹痛は改善傾向となった. フォローの採血が行われ, ビリルビン, 肝酵素の上昇を認めた.
肝炎のスクリーニング採血では有意所見なし.
肝胆道系精査のためMRCPが撮影された. 経過
入院経過と胆嚢炎の疑い
#18. MRCP ・肝内胆管・総胆管拡張なし
・胆管結石なし
・脂肪肝
・胆泥あり, 胆嚢壁の肥厚
・胆嚢周囲に少量の液貯留
#19. 入院3日目, 解熱し腹痛は消退した.T-Bil 5.7mg/dL, D-Bil 2.5mg/dLまで低下し, ALT 292U/L, AST 89U/L, APL 174U/Lまで改善.
メロペネムは中止され、胆嚢摘出術目的に外科へ紹介され退院となった. 経過
#20. めでたしめでたし...
ではない!
一連の経過で違和感はないか?
無石性胆嚢炎の原因とリスク要因
#21. # 無石性胆嚢炎# 一過性のD-bil上昇 (D-bil 11.2/ I-Bil 8.3)
# 脾腫
# Gilbert症候群→間接ビリルビン上昇
# 肥満 (BMI 33)
# 非アルコール性脂肪肝 Problem List
#22. # 無石性胆嚢炎
胆泥形成あり, 発症年齢としては非典型的
# 一過性のD-Bil上昇 (D-Bil 11.2/ I-Bil 8.3)
閉塞はないが高値→一過性の閉塞で説明可能
# 脾腫
脂肪肝のみでは門脈圧亢進で説明困難
# 間接ビリルビン上昇 Gilbert症候群は確定診断?溶血の可能性は?
#23. ・若年性の無石性胆嚢炎の原因 Semantic Qualifier
#24. - 5F (Forty, Female, Fatty, Fair, Fecund・Fertile) 50-60歳代, 肥満傾向の女性, 中心性肥満の男性, 白人, 妊娠, - 胆泥の構成物質の過剰 ビリルビン, コレステロール, カルシウムの過剰
- 薬剤性:フィブラート系, セフトリアキソン, ソマトスタチンアナログ製剤 ホルモン補充療法, 経口避妊薬
- その他:長期間の絶食, 脊髄損傷, 肝硬変, クローン病, 溶血性貧血(I-Bil上昇)
胆泥が溜まる病態 (≒胆石症のリスク) Nezam H Afdhal. Gallstones: Epidemiology, risk factors and prevention: UpToDate →若年性で関与する主な病態は, 溶血性貧血, 脂質異常症, 薬剤性.
遺伝性溶血性貧血の検査結果と考察
#25. 無石性胆嚢炎の原因として, 溶血性貧血は鑑別上位.
脾腫の鑑別として, 溶血性貧血もoverlapする.
Gilbert症候群の診断がついた, 2年前の診療情報を取り寄せた. 経過
#27. I-Bil上昇, LDH上昇, ハプトグロビンの低下あり.Hbは正常のため, 代償された溶血性貧血が疑われた.
精査のため, 網状赤血球数, 血液像の目視を提出した.
家族歴を聴取すると, 父親が27歳の頃に胆石症で胆嚢摘出術を受けていたことが判明した.
#28. Ret 3.2% (正常範囲 0.5~2.2)
網状赤血球絶対数 172,100個/mm3 (正常範囲31,500~108,800)
末梢血塗抹標本:パッペンハイマー小体あり 有棘細胞, 分裂細胞, 球状赤血球は認めず
#29. 網状赤血球数の上昇は, 代償された溶血性貧血を支持する所見.
一方で血液像の目視では, 有意な所見は得られなかった.
父親も若年発症の胆石症の既往があり, 遺伝性疾患が疑われる.
#30. ・遺伝性の溶血性貧血 Semantic Qualifier
遺伝性球状赤血球症の診断と経過
#31. 赤血球膜異常
遺伝性球状赤血球症, 遺伝性楕円赤血球症症候群,遺伝性有口赤血球症, 遺伝性乾燥有口赤血球症 (xerocytosis)
赤血球酵素異常
グルコース-6 リン酸脱水素酵素 (G6PD)欠損症, ピルビン酸キナーゼ (PK)欠損症, グルコースリン酸イソメラーゼ欠損症,
ピリミジン 5’ヌクレオチダーゼ欠損症
赤血球ヘモグロビン異常
鎌状赤血球症候群, サラセミア症候群, 不安定ヘモグロビン症 遺伝性溶血性貧血 Wintrobe’s clinical Hematology, 13th edition, Greer JP, et al, ed. Lippincott Williams & Wilkins, 2014, 606 先天性溶血性貧血の7割が遺伝性球状赤血球症
#32. 4週間後に腹腔鏡下胆嚢摘出術を行った.
複数の色素性胆石があり, 最大1.0cm×0.6cm×0.6cmであった.
周術期に行った末梢血塗抹標本で, 球状赤血球が散在していた. 経過
#33. 赤血球浸透圧抵抗試験:脆弱性が亢進
赤血球EMA(Eosin-5-maleimide)結合能試験:結合能低下
→遺伝性球状赤血球症と診断
直接クームス試験は行われなかった.
7ヶ月後の末梢血塗抹標本では, 多数の球状赤血球を認めた. 経過 東南アジア楕円赤血球症, 先天性赤血球異形成貧血(CDA)Ⅱ型でも低下
#34. 末梢血塗抹標本 7ヶ月後の検体
多数の球状赤血球を認める
胆泥形成と急性胆嚢炎の最終診断
#35. 遺伝性球状赤血球症による
胆泥形成を原因とした急性胆嚢炎 最終診断
#36. ・溶血性貧血は若年性の胆石症のリスク
・貧血を伴わない溶血性貧血
代償された軽症の溶血性貧血では貧血を伴わない
・球状赤血球を認めない球状赤血球症
初期の末梢血塗抹標本では, 球状赤血球は認めなかった
→軽症例の2〜3%では少数のため, 観察されないことがある
Turning Point
#37. ・先天性溶血性貧血の中で最も多く, 7割を占める
・本邦の有病率は人口100万人あたり5.7〜20.3人
・北欧系の人種では2000人に1人
・発症年齢は0~65歳, 20歳以上の発症が40%を占める
・遺伝形式は常染色体優性遺伝, 1/3は遺伝性が確認できず
・本疾患の小児, 若年成人における胆石症の発症率は40% 遺伝性球状赤血球症
#38. ・網状赤血球増加により相殺されてMCV正常が多い
・赤血球浸透圧抵抗試験は10〜20%で正常
・赤血球EMA結合能試験が有用
・重症貧血の場合は, 脾臓摘出術の適応
・感染を契機に溶血発作や, ヒトパルボウイルスB19など による無形成発作を生じることがある 遺伝性球状赤血球症
#39. ・溶血性貧血は胆泥・胆石症のリスク・貧血の無い, 代償性の溶血性貧血という病態がある
・「前医の診断は疑え」 Take home message